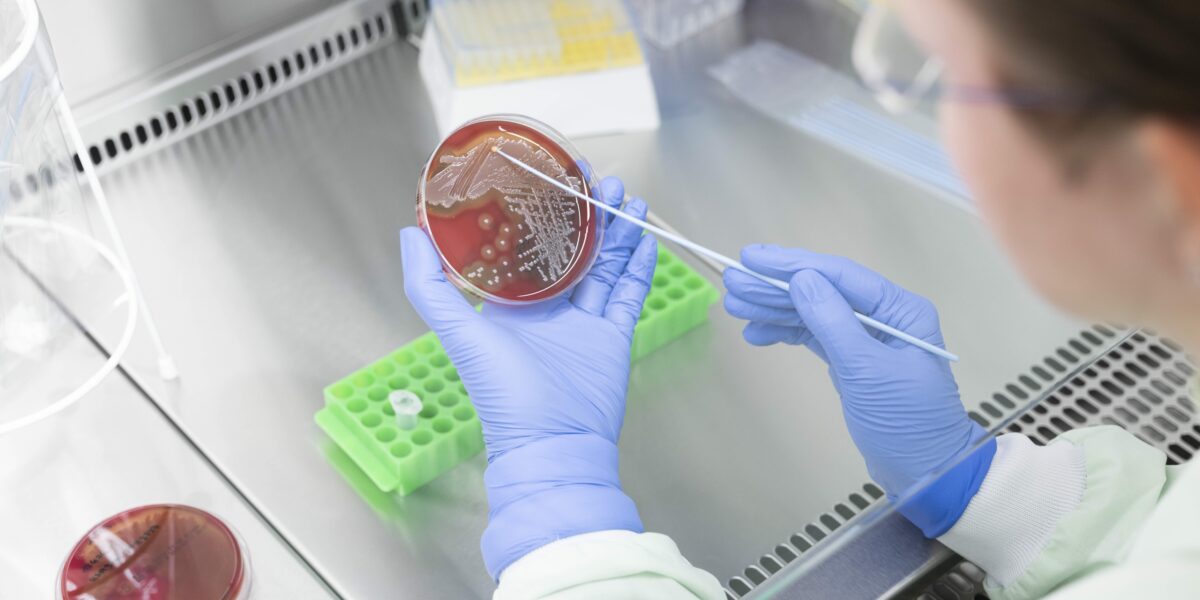
Forschende am Leibniz-IPHT in Jena entwickeln eine Mikroarray-Plattform, die Antibiotikaresistenzen und Impfschutz mit nur einem Tropfen Blut nachweist.

Mini-Chip aus Jena beschleunigt Test auf Antibiotikaresistenz
Antibiotikaresistenz zählt zu den größten Gefahren der modernen Medizin und die Zahl unheilbarer Infektionen steigt. Forschende aus Jena haben nun eine Technologie entwickelt, die die Entwicklung neuer Schnelltests drastisch verkürzt: Mit ihrer Mikroarray-Plattform lassen sich geeignete Antikörper-Paare in Tagen statt Wochen finden.
Forschende am Leibniz-IPHT in Jena entwickeln eine Mikroarray-Plattform, die Antibiotikaresistenzen und Impfschutz mit nur einem Tropfen Blut nachweist.
Foto: Sven Döring/Leibniz-IPHT
Die Plattform entstand am Leibniz-Institut für Photonische Technologien (Leibniz-IPHT) gemeinsam mit 3 Thüringer Diagnostikunternehmen. Der Clou: Ein Tropfen Blut genügt, um Resistenzen und sogar den Impfschutz einer Person zu prüfen. Damit wird in Jena an einer Lösung gearbeitet, die nicht nur das Testen, sondern auch die Entwicklung von Diagnostika selbst in Zukunft einfacher und schneller machen könnte.
„Unsere Plattform verkürzt die Suche nach geeigneten Antikörpern von Wochen auf Tage“, sagt Sascha D. Braun, Erstautor der Studie in Frontiers in Microbiology. „Damit lassen sich neue Tests deutlich schneller entwickeln – ein großer Vorteil angesichts zunehmender Antibiotikaresistenzen.“
Antibiotikaresistenz – Ursache erklärt
Bestimmte Bakterien produzieren sogenannte Carbapenemasen – Enzyme, die fast alle ß-Laktam-Antibiotika, darunter auch Penicilline, unwirksam machen. Diese Resistenzgene sitzen oft auf beweglichen DNA-Elementen und springen zwischen Bakterienarten hin und her, was zu einer schnellen Verbreitung führt. Die WHO stuft solche Arten als kritische Bedrohung ein, weil die Antibiotikaresistenz dazu führt, dass es kaum Therapieoptionen und eine höhere Sterblichkeit gibt.
Mikroarrays – Tests für Antikörper
Mikroarrays funktionieren wie folgt: Auf der Oberfläche eines Chips werden viele verschiedene Antigene oder Enzyme aufgedruckt. Jedes Feld steht dabei für ein anderes Ziel, beispielsweise Masern, Tetanus oder resistente Bakterien. Diese Moleküle dienen als „Köder“ und warten auf passende Antikörper im Blut. Es folgt ein Blutstropfen: Wenn im Blut Antikörper vorhanden sind, binden sie an die passenden Antigene auf dem Chip – so wie ein Schlüssel ins Schloss passt.
Im nächsten Schritt wird ein sogenannter „Sucher-Antikörper“ hinzugegeben, der an bereits gebundene Antikörper bindet und ein Leuchtsignal erzeugt. Dieses Signal wird von einem Gerät gemessen – je stärker das Leuchten, desto mehr Antikörper sind vorhanden.
Deutlich schnellere Tests möglich
Das Neue an der Jenaer Entwicklung ist nicht nur, dass sie Erreger schnellt erkennt, sondern wie sie das tut: Die Mikroarray-Plattform beschleunigt die Entwicklung der Tests selbst. Statt jeden einzelnen Antikörper einzeln zu prüfen, testet der Chip Dutzende gleichzeitig – sowohl als „Köder“ (bindende Komponente) als auch als „Sucher“ (detektierende Komponente).
Das spart Zeit und viele Einzelschritte, die klassische Tests erfordern. Rund ein Fünftel der 49 in der Studie getesteten Antikörper zeigte starke, reproduzierbare Signale. Damit eignen sich diese für den Einsatz in Schnelltests wie Lateral-Flow-Streifen. Ziel ist dabei, Testergebnisse künftig innerhalb weniger Minuten zu erhalten, bei gleichzeitig hoher Spezifität und Sensitivität.
Die Technologie wurde in Kooperation mit INTER-ARRAY by fzmb (Bad Langensalza), Senova (Weimar) und -4H-JENA engineering entwickelt. INTER-ARRAY war maßgeblich an der Entwicklung der Antikörper und Mikroarrays beteiligt, Senova und -4H-JENA engineering brachten ihr Know-how in der Lateral-Flow-Assay-Entwicklung und Systemintegration von Diagnostiklösungen ein.
Das Leibniz-IPHT übernahm die vollständige Assayentwicklung, von der Auswahl geeigneter Zielmoleküle über die Etablierung sensitiver Nachweisverfahren bis zur Validierung unter praxisnahen Bedingungen.
Auch ein Indikator für Impfschutz
Bereits 2022 hatten die Forschenden mit der Mikroarray-Technologie gezeigt, dass sich Antikörper gegen Impfstoffe und Infektionen wie Masern, Tetanus oder SARS-CoV-2 nachweisen lassen. Ziel war es, die Antikörperbildung im Blut nach einer Impfung sichtbar zu machen. Ein Tropfen Blut genügt, um zu zeigen, ob ausreichend Impfschutz besteht: Auf dem Chip fixierte Antigene wirken als molekulare „Fallen“, an die passende Antikörper binden.
Diese Anwendung ist hochaktuell: Laut WHO und Unicef wurden 2024 über 127.000 Masernfälle in der europäischen WHO-Region gemeldet, doppelt so viele wie im Vorjahr. Sinkende Impfquoten nach der Corona-Pandemie verschärfen das Problem. Mit der Plattform könnten Impflücken künftig gezielt aufgedeckt werden, etwa bei Schuleingangsuntersuchungen oder Gesundheitschecks für Menschen mit unklarem Impfstatus.
Ein Beitrag von:












